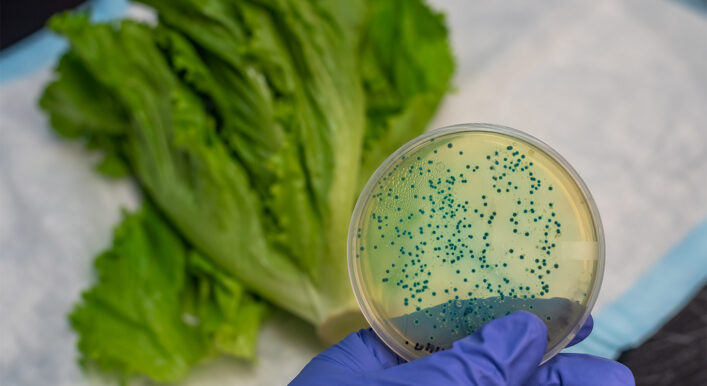

- All
- News
- ΗΑCCP
- Υγιεινομική νομοθεσία

07/01/2026
Νέος Κανονισμός ΕΕ για τη Συσκευασία (PPWR)
Πρόκειται για Κανονισμό (ΕΕ) 2025/40 για τις συσκευασίες & τα απόβλητα συσκευασίας (PPWR) Τι σημαίνει για τις επιχειρήσεις τροφίμων με απλά λόγια Η Ευρωπαϊκή Ένωση φέρνει έναν νέο Κανονισμό για τις συσκευασίες (PPWR), που αλλάζει τον τρόπο με τον οποίο οι επιχειρήσεις τροφίμων χρησιμοποιούν και πετάνε τις συσκευασίες τους. Βασική ιδέα: Μέχρι το 2030, όλες [...]

07/01/2026
Παράταση προθεσμίας OpenBusiness έως 31/12/2026
Παράταση προθεσμίας στο Open Business έως 31/12/2026 Απογραφή επιχείρησης & ανάρτηση δικαιολογητικών. Το Υπουργείο Ανάπτυξης και Επενδύσεων ανακοίνωσε παράταση της προθεσμίας έως 31/12/2026 για: την απογραφή υφιστάμενων δραστηριοτήτων στο πληροφοριακό σύστημα OpenBusiness, και την ανάρτηση δικαιολογητικών γνωστοποίησης λειτουργίας για τις επιχειρήσεις που υπάγονται στον Ν. 4442/2016. Η Safety Line (Σύμβουλοι Ποιότητας & Υγιεινής Τροφίμων), ενημερώνει [...]
04/06/2024
Νομοθεσία για την Listeria στα τρόφιμα ready to eat
Έγινε τροποποίηση του κανονισμού (ΕΚ) αριθ. 2073/2005 όσον αφορά τη Listeria monocytogenes στα ready to eat foods. Σκοπός είναι να εξασφαλιστεί το ίδιο επίπεδο προστασίας της δημόσιας υγείας από την παραγωγή έως τη διανομή για έτοιμα προς κατανάλωση τρόφιμα. Το επίπεδο της Listeria monocytogenes δεν θα υπερβαίνει το όριο των 100 cfu/g καθ' όλη τη [...]

04/06/2024
Ο κίνδυνος της σαλμονέλας δεν είναι μόνο στα πουλερικά…
Η σαλμονέλα είναι ένα κοινό βακτήριο που βρίσκεται στα έντερα των ζώων και των ανθρώπων και αποβάλλεται μέσω των κοπράνων. Προκαλεί τροφική δηλητηρίαση (Σαλμονέλωση) στον άνθρωπο λόγω ανεπαρκούς μαγειρέματος ή διασταυρούμενης μόλυνσης. Συνήθεις πηγές είναι το μολυσμένο νερό, το ωμό/μη μαγειρεμένο κρέας (ιδιαίτερα τα πουλερικά) ή τα αυγά και το μη παστεριωμένο γάλα. Νέοι, ηλικιωμένοι [...]

04/06/2024
Τρόφιμα που βοηθούν στις αλλεργίες
Ποιες είναι οι 5 κατηγορίες τροφίμων που ανακουφίζουν τις αλλεργίες σύμφωνα με τους διατροφολόγους; Οι εποχιακές αλλεργίες οφείλονται ως επί τω πλείστω σε αλλεργικές αντιδράσεις στη σκόνη (αφρικανική σκόνη) και τη γύρη ή τα χόρτα και ορισμένα φυτά που βρίσκονται στο περιβάλλον μας και προκαλούν συμπτώματα, όπως ρινική καταρροή, μπούκωμα και πολλές φορές ξηρότητα στο λαιμό. Πολλοί γιατροί συμβουλεύουν τους ασθενείς [...]

04/06/2024
Υπολλείματα Φυτοφαρμάκων σε Ελληνικά φρούτα και λαχανικά
ΈΛΕΓΧΟΙ ΤΟΥ ΥΠΑΑΤ ΓΙΑ ΤΟ ΑΠΡΙΛΙΟ 2024 Δόθηκαν στη δημοσιότητα από το Υπουργείο Αγροτικής Ανάπτυξης και Τροφίμων τα αποτελέσματα των ελέγχων που έγιναν τον Απρίλιο 2024, για παρουσία φυτοφαρμάκων μέσα ή πάνω σε τρόφιμα φυτικής προέλευσης. Τον τέταρτο μήνα του 2024 διενεργήθηκαν έλεγχοι σε 420 δείγματα τροφίμων (τον Μάρτιο ελέγχθηκαν 280 δείγματα φρούτων και λαχανικών), εκ των [...]

04/06/2024
Επιπτώσεις στην υγεία από την κατανάλωση κόκκινου κρέατος
ΠΟΣΟ ΚΟΚΚΙΝΟ ΚΡΕΑΣ ΑΝΤΕΧΕΙ Ο ΑΝΡΘΩΠΙΝΟΣ ΟΡΓΑΝΙΣΜΟΣ? Τις τελευταίες δεκαετίες, η κατανάλωση κόκκινου κρέατος έχει αυξηθεί παγκοσμίως, ιδιαίτερα στις αναπτυσσόμενες χώρες. Η κατανάλωση κόκκινου κρέατος (μοσχάρι, χοιρινό, αρνί και κατσίκι) συνεισφέρει αρκετά σημαντικά θρεπτικά συστατικά στη διατροφή, για παράδειγμα απαραίτητα αμινοξέα, βιταμίνες (συμπεριλαμβανομένης της Β12) και μέταλλα (συμπεριλαμβανομένου του σιδήρου και του ψευδαργύρου). Όμως υπάρχουν [...]

04/06/2024
Ζώα Συντροφιάς σε χώρους εστίασης
Σε ποιες περιπτώσεις επιτρέπεται η είσοδος των ζώων συντροφιάς σε Καταστήματα Υγειονομικού Ενδιαφέροντος. Είναι πλέον αρκετά σύνηθες το φαινόμενο, ειδικά το καλοκαίρι που ο κόσμος βγαίνει για περίπατο και βόλτα, να δημιουργείται έντονη αντιπαράθεση μεταξύ επιχειρηματιών καταστημάτων υγειονομικού ενδιαφέροντος και κάποιων καλεσμένων τους οι οποίοι επιθυμούν να εισέλθουν στον χώρο της αίθουσας πελατών της εγκατάστασης [...]

04/06/2024
Νέα όρια στη Μυκοτοξίνη ”Don” για τα τρόφιμα φυτικής προέλευσης
Στις 9/4/2024, δημοσιεύτηκε από την Ευρωπαϊκή Επιτροπή, ο νέος Κανονισμός (ΕΕ) 2024/1022 για την τροποποίηση του κανονισμού (ΕΕ) 2023/915, όσον αφορά τα μέγιστα επιτρεπτά επίπεδα δεσοξυνιβαλενόλης (DON) στα τρόφιμα. Η δεοξυνιβαλενόλη (DON) είναι μία από τις πολλές μυκοτοξίνες που παράγονται από ορισμένα είδη Fusarium που μολύνουν συχνά το καλαμπόκι, το σιτάρι, τη βρώμη, το κριθάρι, [...]

04/06/2024
Υποχρέωση τήρησης ΔΕΛΤΙΟ ΠΑΡΑΠΟΝΩΝ πελατών από τα κέντρα και καταστήματα εστίασης, αναψυχής και διασκέδασης.
Τα κέντρα και καταστήματα εστίασης, αναψυχής και διασκέδασης υποχρεούνται να διαθέτουν προς χρήση της πελατείας τους το ειδικό έντυπο «ΦΥΛΛO ΔΙΑΜΑΡΤΥΡΙΑΣ». Το έντυπο αυτό διατίθεται, μέσω ειδικής θήκης, τοποθετημένης σε εμφανές μέρος για τους πελάτες, δίπλα ακριβώς από την έξοδο του καταστήματος. Το έντυπο «ΦΥΛΛO ΔΙΑΜΑΡΤΥΡΙΑΣ» είναι αριθμημένο τριπλότυπο με τρία φύλλα διαφορετικού χρώματος το [...]

04/06/2024
Νομοθεσία για τα Πλαστικά στην Εστίαση
Ο νόμος 4736/2020 με τίτλο «Ενσωμάτωση της Οδηγίας 2019/904/ΕΕ σχετικά με τη μείωση των επιπτώσεων ορισμένων πλαστικών προϊόντων στο περιβάλλον και άλλες διατάξεις» ψηφίστηκε τον Οκτώβριο 2020, με στόχο του Υπουργείου Περιβάλλοντος και Ενέργειας, την καταπολέμηση της πλαστικής ρύπανσης. Ειδικότερα προβλέπονται τα εξής: Α. Για τα ακόλουθα 10 προϊόντα απαγορεύεται η διάθεσή τους στην επικράτεια και σε όλες [...]

04/06/2024
Πυροπροστασία για Καταστήματα Υγειονομικού Ενδιαφέροντος.
Η νομοθεσία ορίζει νέο καθεστώς στον τομέα της πυρασφάλειας! Οι φορείς των δραστηριοτήτων που υπάγονται στην κατηγορία Α (χαμηλού κινδύνου) και που στεγάζονται σε υφιστάμενα κτίρια (οικοδομική άδεια πριν 02/1989), απαλλάσσονται από την υποχρέωση σύνταξης μελέτης ενεργητικής πυροπροστασίας – σχεδίων κατόψεων και σύνταξης συνοπτικής μελέτης αποθήκευσης υγραερίου. Αλλά οφείλουν να τηρούν και να συντηρούν τα [...]
